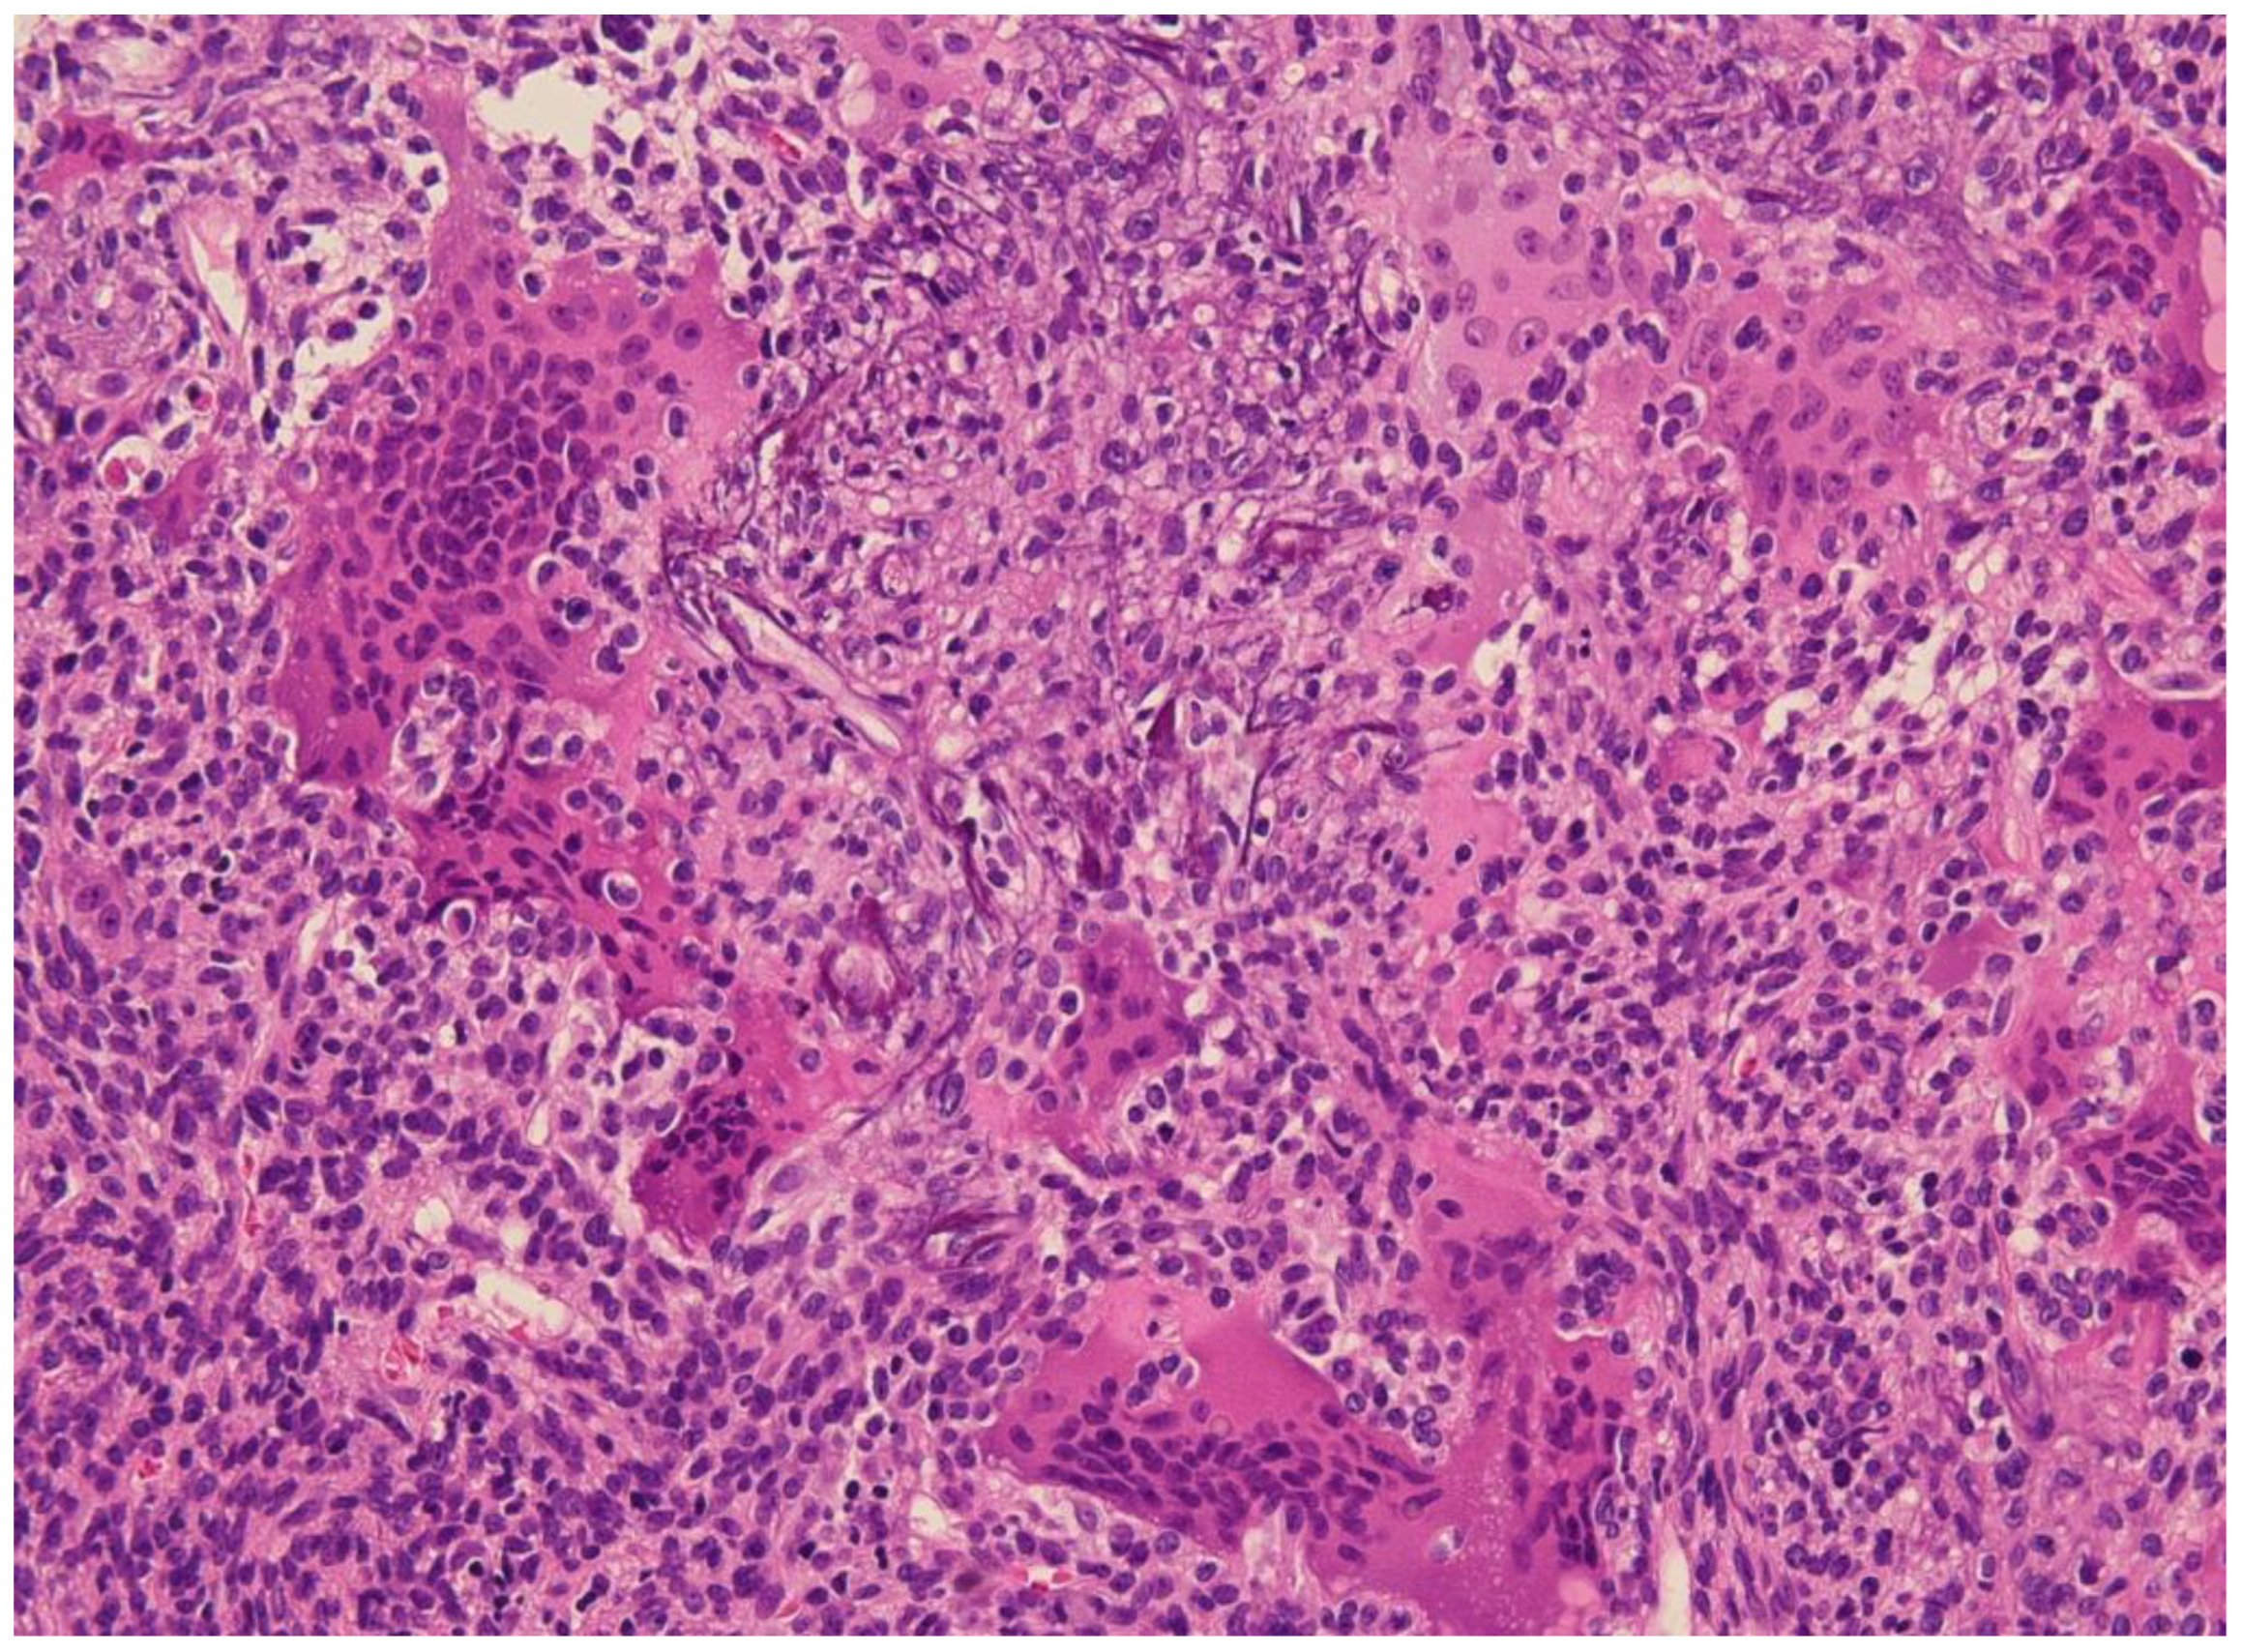
Curroncol 30 00541 g002

Phosphaturic Mesenchymal Tumors with or without Phosphate Metabolism Derangements
Abstract
1. Introduction
2. Clinical Characteristics
3. Imaging and Radiological Features of PMTs
4. Surgery and Non-Surgical Alternatives
5. Histology
6. Medical Treatment
6.1. Conventional Treatment
6.2. Novel and Potential Treatments for Tumor-Induced Osteomalacia
7. Conclusions
Author Contributions
Funding
Institutional Review Board Statement
Informed Consent Statement
Data Availability Statement
Conflicts of Interest
References
- Folpe, A.L. Phosphaturic mesenchymal tumors: A review and update. Semin. Diagn. Pathol. 2019, 36, 260–268. [Google Scholar] [CrossRef] [PubMed]
- Salassa, R.M.; Jowsey, J.; Arnaud, C.D. Hypophosphatemic Osteomalacia Associated with Nonendocrine Tumors. N. Engl. J. Med. 1970, 283, 65–70. [Google Scholar] [CrossRef] [PubMed]
- Ryan, E.A.; Reiss, E. Oncogenous osteomalacia: Review of the world literature of 42 cases and report of two new cases. Am. J. Med. 1984, 77, 501–512. [Google Scholar] [CrossRef]
- Brandi, M.L.; Clunie, G.P.; Houillier, P.; de Beur, S.M.J.; Minisola, S.; Oheim, R.; Seefried, L. Challenges in the management of tumor-induced osteomalacia (TIO). Bone 2021, 152, 116064. [Google Scholar] [CrossRef]
- Jagtap, V.S.; Sarathi, V.; Lila, A.R.; Malhotra, G.; Sankhe, S.S.; Bandgar, T.; Menon, P.; Shah, N.S. Tumor-induced osteomalacia: A single center experience. Endocr. Pract. 2011, 17, 177–184. [Google Scholar] [CrossRef]
- Jiang, Y.; Xia, W.-B.; Xing, X.-P.; Silva, B.C.; Li, M.; Wang, O.; Zhang, H.-B.; Li, F.; Jing, H.-L.; Zhong, D.-R.; et al. Tumor-induced osteomalacia: An important cause of adult-onset hypophosphatemic osteomalacia in China: Report of 39 cases and review of the literature. J. Bone Miner. Res. 2012, 27, 1967–1975. [Google Scholar] [CrossRef]
- Reyes-Múgica, M.; Arnsmeier, S.L.; Backeljauw, P.F.; Persing, J.; Ellis, B.; Carpenter, T.O. Phosphaturic Mesenchymal Tumor-Induced Rickets. Pediatr. Dev. Pathol. 2000, 3, 61–69. [Google Scholar] [CrossRef]
- Terek, R.M.; Nielsen, G.P. Case 29-2001. N. Engl. J. Med. 2001, 345, 903–908. [Google Scholar] [CrossRef] [PubMed]
- Bosman, A.; Palermo, A.; Vanderhulst, J.; De Beur, S.M.J.; Fukumoto, S.; Minisola, S.; Xia, W.; Body, J.-J.; Zillikens, M.C. Tumor-Induced Osteomalacia: A Systematic Clinical Review of 895 Cases. Calcif. Tissue Int. 2022, 111, 367–379. [Google Scholar] [CrossRef] [PubMed]
- McCance, R.A. Osteomalacia with Looser’s nodes (Milkman’s syndrome) due to a raised resistance to vitamin D acquired about the age of 15 years. Q. J. Med. 1947, 16, 33–46. [Google Scholar]
- Brunelli, S.M.; Goldfarb, S. Hypophosphatemia. J. Am. Soc. Nephrol. 2007, 18, 1999–2003. [Google Scholar] [CrossRef] [PubMed]
- Halevy, J.; Bulvik, S. Severe Hypophosphatemia in Hospitalized Patients. Arch. Intern. Med. 1988, 148, 153–155. [Google Scholar] [CrossRef] [PubMed]
- Imel, E.A.; Econs, M.J. Approach to the Hypophosphatemic Patient. J. Clin. Endocrinol. Metab. 2012, 97, 696–706. [Google Scholar] [CrossRef] [PubMed]
- Zavatta, G.; Altieri, P.; Vandi, G.; Vicennati, V.; Pagotto, U.; Vescini, F. Phosphate Metabolism and Pathophysiology in Parathyroid Disorders and Endocrine Tumors. Int. J. Mol. Sci. 2021, 22, 12975. [Google Scholar] [CrossRef]
- Tenenhouse, H.S. Cellular and Molecular Mechanisms of Renal Phosphate Transport. J. Bone Miner. Res. 1997, 12, 159–164. [Google Scholar] [CrossRef]
- Rendina, D.; De Filippo, G.; Tauchmanovà, L.; Insabato, L.; Muscariello, R.; Gianfrancesco, F.; Esposito, T.; Cioffi, M.; Colao, A.; Strazzullo, P.; et al. Bone Turnover and the Osteoprotegerin–RANKL Pathway in Tumor-Induced Osteomalacia: A Longitudinal Study of Five Cases. Calcif. Tissue Int. 2009, 85, 293–300. [Google Scholar] [CrossRef]
- Zanchetta, M.B.; Jerkovich, F.; Nuñez, S.; Mocarbel, Y.; Pignatta, A.; Elías, N.; Díaz, A.G.; Roganovich, J.M.; Vigovich, C.; Balonga, M.C.; et al. Impaired bone microarchitecture and strength in patients with tumor-induced osteomalacia. J. Bone Miner. Res. 2021, 36, 1502–1509. [Google Scholar] [CrossRef]
- Schini, M.; Vilaca, T.; Gossiel, F.; Salam, S.; Eastell, R. Bone Turnover Markers: Basic Biology to Clinical Applications. Endocr. Rev. 2022, 44, 417–473. [Google Scholar] [CrossRef]
- Kilbane, M.T.; Crowley, R.; Heffernan, E.; D’Arcy, C.; O’Toole, G.; Twomey, P.J.; McKenna, M.J. High bone turnover and hyperparathyroidism after surgery for tumor-induced osteomalacia: A case series. Bone Rep. 2021, 15, 101142. [Google Scholar] [CrossRef]
- Xiang, Z.; Wang, M.; Miao, C.; Jin, D.; Wang, H. Mechanism of calcitriol regulating parathyroid cells in secondary hyperparathyroidism. Front. Pharmacol. 2022, 13, 1020858. [Google Scholar] [CrossRef]
- Boland, J.M.; Tebben, P.J.; Folpe, A.L. Phosphaturic mesenchymal tumors: What an endocrinologist should know. J. Endocrinol. Investig. 2018, 41, 1173–1184. [Google Scholar] [CrossRef] [PubMed]
- Jonsson, K.B.; Zahradnik, R.; Larsson, T.; White, K.E.; Sugimoto, T.; Imanishi, Y.; Yamamoto, T.; Hampson, G.; Koshiyama, H.; Ljunggren, Ö.; et al. Fibroblast Growth Factor 23 in Oncogenic Osteomalacia and X-Linked Hypophosphatemia. N. Engl. J. Med. 2003, 348, 1656–1663. [Google Scholar] [CrossRef]
- De Beur, S.M.J. Tumor-induced osteomalacia. JAMA 2005, 294, 1260–1267. [Google Scholar] [CrossRef] [PubMed]
- Amblee, A.; Uy, J.; Senseng, C.; Hart, P. Tumor-induced osteomalacia with normal systemic fibroblast growth factor-23 level. Clin. Kidney J. 2014, 7, 186–189. [Google Scholar] [CrossRef]
- Bansal, S.; Khazim, K.; Suri, R.; Martin, D.; Werner, S.; Fanti, P. Tumor induced osteomalacia: Associated with elevated circulating levels of fibroblast growth factor-7 in addition to fibroblast growth factor-23. Clin. Nephrol. 2016, 85, 57–62. [Google Scholar] [CrossRef] [PubMed]
- White, K.E.; Larsson, T.E.; Econs, M.J. The Roles of Specific Genes Implicated as Circulating Factors Involved in Normal and Disordered Phosphate Homeostasis: Frizzled Related Protein-4, Matrix Extracellular Phosphoglycoprotein, and Fibroblast Growth Factor 23. Endocr. Rev. 2006, 27, 221–241. [Google Scholar] [CrossRef]
- Berndt, T.; Craig, T.A.; Bowe, A.E.; Vassiliadis, J.; Reczek, D.; Finnegan, R.; De Beur, S.M.J.; Schiavi, S.C.; Kumar, R. Secreted frizzled-related protein 4 is a potent tumor-derived phosphaturic agent. J. Clin. Investig. 2003, 112, 785–794. [Google Scholar] [CrossRef]
- Lee, J.-C.; Jeng, Y.-M.; Su, S.-Y.; Wu, C.-T.; Tsai, K.-S.; Lee, C.-H.; Lin, C.-Y.; Carter, J.M.; Huang, J.-W.; Chen, S.-H.; et al. Identification of a novel FN1-FGFR1 genetic fusion as a frequent event in phosphaturic mesenchymal tumour. J. Pathol. 2015, 235, 539–545. [Google Scholar] [CrossRef]
- Lee, J.-C.; Su, S.-Y.; Changou, C.A.; Yang, R.-S.; Tsai, K.-S.; Collins, M.T.; Orwoll, E.S.; Lin, C.-Y.; Chen, S.-H.; Shih, S.-R.; et al. Characterization of FN1–FGFR1 and novel FN1–FGF1 fusion genes in a large series of phosphaturic mesenchymal tumors. Mod. Pathol. 2016, 29, 1335–1346. [Google Scholar] [CrossRef]
- de Beur, S.M.J.; Minisola, S.; Xia, W.; Abrahamsen, B.; Body, J.; Brandi, M.L.; Clifton-Bligh, R.; Collins, M.; Florenzano, P.; Houillier, P.; et al. Global guidance for the recognition, diagnosis, and management of tumor-induced osteomalacia. J. Intern. Med. 2022, 293, 309–328. [Google Scholar] [CrossRef]
- Shi, Z.; Deng, Y.; Li, X.; Li, Y.; Cao, D.; Coossa, V.S. CT and MR imaging features in phosphaturic mesenchymal tumor-mixed connective tissue: A case report. Oncol. Lett. 2018, 15, 4970–4978. [Google Scholar] [CrossRef]
- Peterson, N.R.; Summerlin, D.-J.; Cordes, S.R. Multiple phosphaturic mesenchymal tumors associated with oncogenic osteomalacia: Case report and review of the literature. Ear Nose Throat J. 2010, 89, E11–E15. [Google Scholar]
- Hendry, D.S.; Wissman, R. Case 165: Oncogenic Osteomalacia. Radiology 2011, 258, 320–322. [Google Scholar] [CrossRef]
- Fatani, H.A.; Sunbuli, M.; Lai, S.Y.; Bell, D. Phosphaturic mesenchymal tumor: A report of 6 patients treated at a single institution and comparison with reported series. Ann. Diagn. Pathol. 2013, 17, 319–321. [Google Scholar] [CrossRef]
- Agrawal, K.; Bhadada, S.; Mittal, B.R.; Shukla, J.; Sood, A.; Bhattacharya, A.; Bhansali, A. Comparison of 18F-FDG and 68Ga DOTATATE PET/CT in Localization of Tumor Causing Oncogenic Osteomalacia. Clin. Nucl. Med. 2015, 40, e6–e10. [Google Scholar] [CrossRef]
- El-Maouche, D.; Sadowski, S.M.; Papadakis, G.Z.; Guthrie, L.; Cottle-Delisle, C.; Merkel, R.; Millo, C.; Chen, C.C.; Kebebew, E.; Collins, M.T. 68Ga-DOTATATE for Tumor Localization in Tumor-Induced Osteomalacia. J. Clin. Endocrinol. Metab. 2016, 101, 3575–3581. [Google Scholar] [CrossRef]
- Nakanishi, K.; Sakai, M.; Tanaka, H.; Tsuboi, H.; Hashimoto, J.; Hashimoto, N.; Tomiyama, N. Whole-body MR Imaging in Detecting Phosphaturic Mesenchymal Tumor (PMT) in Tumor-induced Hypophosphatemic Osteomalacia. Magn. Reson. Med. Sci. 2013, 12, 47–52. [Google Scholar] [CrossRef]
- Broski, S.M.; Folpe, A.L.; Wenger, D.E. Imaging features of phosphaturic mesenchymal tumors. Skelet. Radiol. 2018, 48, 119–127. [Google Scholar] [CrossRef]
- Clunie, G.P.R.; Fox, P.E.; Stamp, T.C.B. Four cases of acquired hypophosphataemic (‘oncogenic’) osteomalacia. Problems of diagnosis, treatment and long-term management. Rheumatology 2000, 39, 1415–1421. [Google Scholar] [CrossRef]
- Ogose, A.; Hotta, T.; Emura, I.; Hatano, H.; Inoue, Y.; Umezu, H.; Endo, N. Recurrent malignant variant of phosphaturic mesenchymal tumor with oncogenic osteomalacia. Skelet. Radiol. 2001, 30, 99–103. [Google Scholar] [CrossRef]
- Uramoto, N.; Furukawa, M.; Yoshizaki, T. Malignant phosphaturic mesenchymal tumor, mixed connective tissue variant of the tongue. Auris Nasus Larynx 2009, 36, 104–105. [Google Scholar] [CrossRef]
- Khosravi, A.; Cutler, C.M.; Kelly, M.H.; Chang, R.; Royal, R.E.; Sherry, R.M.; Wodajo, F.M.; Fedarko, N.S.; Collins, M.T. Determination of the Elimination Half-Life of Fibroblast Growth Factor-23. J. Clin. Endocrinol. Metab. 2007, 92, 2374–2377. [Google Scholar] [CrossRef]
- Chong, W.H.; Molinolo, A.A.; Chen, C.C.; Collins, M.T. Tumor-induced osteomalacia. Endocr. -Relat. Cancer 2011, 18, R53–R77. [Google Scholar] [CrossRef]
- Hesse, E.; Rosenthal, H.; Bastian, L. Radiofrequency Ablation of a Tumor Causing Oncogenic Osteomalacia. N. Engl. J. Med. 2007, 357, 422–424. [Google Scholar] [CrossRef]
- Sutcliffe, R.P.; Dickson, J.C.; Layfield, R.; Almond, L.M.; Rutherford, J.M.; Bradley, K.M. Radiofrequency Ablation for the Treatment of Phosphaturic Mesenchymal Tumours: A Case Series. J. Bone Oncol. 2017, 9, 20–24. [Google Scholar]
- Li, X.; Li, Y.; Wu, Y. Percutaneous Radiofrequency Ablation for Phosphaturic Mesenchymal Tumors: A Case Report and Literature Review. Chin. J. Cancer Res. 2020, 32, 307–313. [Google Scholar] [CrossRef]
- Folpe, A.L.; Fanburg-Smith, J.C.; Billings, S.D.; Bisceglia, M.; Bertoni, F.; Cho, J.Y.B.; Econs, M.J.; Inwards, C.Y.; de Beur, S.M.J.; Mentzel, T.; et al. Most Osteomalacia-associated Mesenchymal Tumors Are a Single Histopathologic Entity: An analysis of 32 cases and a comprehensive review of the literature. Am. J. Surg. Pathol. 2004, 28, 1–30. [Google Scholar] [CrossRef]
- Harvey, J.N.; Gray, C.; Belchetz, P.E. Oncogenous osteomalacia and malignancy. Clin. Endocrinol. 1992, 37, 379–384. [Google Scholar] [CrossRef]
- Weidner, N.; Santa Cruz, D. Phosphaturic mesenchymal tumors. A polymorphous group causing osteomalacia or rickets. Cancer 1987, 59, 1442–1454. [Google Scholar] [CrossRef]
- Agaimy, A.; Michal, M.; Chiosea, S.; Petersson, F.; Hadravsky, L.; Kristiansen, G.; Horch, R.E.; Schmolders, J.; Hartmann, A.; Haller, F. Phosphaturic Mesenchymal Tumors: Clinicopathologic, Immunohistochemical and Molecular Analysis of 22 Cases Expanding their Morphologic and Immunophenotypic Spectrum. Am. J. Surg. Pathol. 2017, 41, 1371–1380. [Google Scholar] [CrossRef]
- Salim, M.; Behairy, M.S.; Barengolts, E. TIO Associated with Hyperparathyroidism: A Rarity, a Rule, or a Novel HPT-PMT Syndrome—A Case Study with Literature Review. Case Rep. Endocrinol. 2021, 2021, 5172131. [Google Scholar] [CrossRef]
- de Beur, S.M.J.; Miller, P.D.; Weber, T.J.; Peacock, M.; Insogna, K.; Kumar, R.; Rauch, F.; Luca, D.; Cimms, T.; Roberts, M.S.; et al. Burosumab for the Treatment of Tumor-Induced Osteomalacia. J. Bone Miner. Res. 2020, 36, 627–635. [Google Scholar] [CrossRef] [PubMed]
- Imanishi, Y.; Ito, N.; Rhee, Y.; Takeuchi, Y.; Shin, C.S.; Takahashi, Y.; Onuma, H.; Kojima, M.; Kanematsu, M.; Kanda, H.; et al. Interim Analysis of a Phase 2 Open-Label Trial Assessing Burosumab Efficacy and Safety in Patients with Tumor-Induced Osteomalacia. J. Bone Miner. Res. 2020, 36, 262–270. [Google Scholar] [CrossRef] [PubMed]
- Heijboer, A.C.; Cavalier, E. The Measurement and Interpretation of Fibroblast Growth Factor 23 (FGF23) Concentrations. Calcif. Tissue Int. 2022, 112, 258–270. [Google Scholar] [CrossRef]
- Carli, D.; Cardaropoli, S.; Tessaris, D.; Coppo, P.; La Selva, R.; Cesario, C.; Lepri, F.R.; Pullano, V.; Palumbo, M.; Ramenghi, U.; et al. Successful treatment with MEK-inhibitor in a patient with NRAS -related cutaneous skeletal hypophosphatemia syndrome. Genes Chromosom. Cancer 2022, 61, 740–746. [Google Scholar] [CrossRef]
- Liu, S.-H.; Xiao, Z.; Mishra, S.K.; Mitchell, J.C.; Smith, J.C.; Quarles, L.D.; Petridis, L. Identification of Small-Molecule Inhibitors of Fibroblast Growth Factor 23 Signaling via In Silico Hot Spot Prediction and Molecular Docking to α-Klotho. J. Chem. Inf. Model. 2022, 62, 3627–3637. [Google Scholar] [CrossRef]

| Laboratory Parameter | Expected Alteration |
|---|---|
| Serum phosphate | Decreased |
| Urinary phosphate | Inappropriately normal or increased in relation to low serum phosphate |
| Serum calcium | In the lower half on the normal range or slightly decreased |
| Serum alkaline phosphatase (ALP) | Increased |
| FGF-23 (intact) | Increased or inappropriately normal |
| FGF-23 (C-terminal) | Increased |
| 1,25(OH)2 vitamin D | Decreased or inappropriately normal in relation to low serum phosphate |
| 25(OH) vitamin D | Variable. It depends on dietary intake and sun exposure |
| TmP/GFR a | Decreased |
| FEP | Increased |
Disclaimer/Publisher’s Note: The statements, opinions and data contained in all publications are solely those of the individual author(s) and contributor(s) and not of MDPI and/or the editor(s). MDPI and/or the editor(s) disclaim responsibility for any injury to people or property resulting from any ideas, methods, instructions or products referred to in the content. |
© 2023 by the authors. Licensee MDPI, Basel, Switzerland. This article is an open access article distributed under the terms and conditions of the Creative Commons Attribution (CC BY) license (https://creativecommons.org/licenses/by/4.0/).
Share and Cite
Montanari, A.; Pirini, M.G.; Lotrecchiano, L.; Di Prinzio, L.; Zavatta, G. Phosphaturic Mesenchymal Tumors with or without Phosphate Metabolism Derangements. Curr. Oncol. 2023, 30, 7478-7488. https://doi.org/10.3390/curroncol30080541
Montanari A, Pirini MG, Lotrecchiano L, Di Prinzio L, Zavatta G. Phosphaturic Mesenchymal Tumors with or without Phosphate Metabolism Derangements. Current Oncology. 2023; 30(8):7478-7488. https://doi.org/10.3390/curroncol30080541
Chicago/Turabian StyleMontanari, Andrea, Maria Giulia Pirini, Ludovica Lotrecchiano, Lorenzo Di Prinzio, and Guido Zavatta. 2023. "Phosphaturic Mesenchymal Tumors with or without Phosphate Metabolism Derangements" Current Oncology 30, no. 8: 7478-7488. https://doi.org/10.3390/curroncol30080541
APA StyleMontanari, A., Pirini, M. G., Lotrecchiano, L., Di Prinzio, L., & Zavatta, G. (2023). Phosphaturic Mesenchymal Tumors with or without Phosphate Metabolism Derangements. Current Oncology, 30(8), 7478-7488. https://doi.org/10.3390/curroncol30080541





